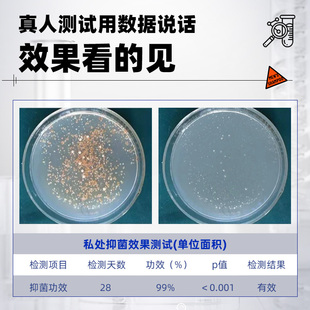

私处清洗液男性清洁抑菌日常私护洗护液止痒私密处护理液杀菌 男士由淘宝网为您挑选。折后价格89元,已有0人购买,选自掌柜国货严选旗舰 。
⭐小红书推荐⭐私处清洗液男性清洁抑菌日常私护洗护液止痒私密处护理液杀菌 男士,所属私处洗液分类,由淘宝网挑选推荐!小红书抖音网红同款!哪里有卖私处清洗液男性清洁抑菌日常私护洗护液止痒私密处护理液杀菌 男士和多少钱质量怎么样✅。 妇炎洁私处清洗液女私密护理液外阴清洁益生菌洗液女性日常洗护液 妇炎洁私处洗护液女性护理清洗液冲洗抑菌止痒私密清洗剂官方正品 私处护理清洗液男性清洁抑菌私密沐浴露日常抑菌洗护液 妇炎洁男士 蔓越莓私处洗护液私密护理液护理日常清洗液女性去异味官方正品 妇炎洁男士 私处护理液私密清洗液沐浴露便携清洁液60g 天猫U先 妇炎洁私处洗护液女泡沫慕斯益生菌洗液日常私密护理液私处清洗液 宫本武藏蔓越莓私密护理女性益生菌呵护私处清洗液官方旗舰店正品 妇炎洁私处清洗液洗护液女性抑菌可内外阴清洗私密护理液官方正品 妇炎洁雪莲抑霉菌私处清洗液女性私密护理液外阴清洁洗剂洗护洗液 洁尔阴女性私处洗护私部护理液清洗外阴女日常私密洗液洗私洁阴 毓婷私处洗护液私密护理液外阴清洗液女日常洗护妇科洗液私处护理 妇炎洁女性私处清洗液私密部日常护理液本草抑菌680ml 瓶官方正品 intima茵缇玛私处洗护液私密护理液私处日常洗护沐浴露清洗液女性 海洋至尊男士 私处护理清洗液清洁抑菌洗下面私密便携 明星同款 妇炎洁私处清洗液女私护清洁液益生菌私密护理液抑菌止痒日常洗护



https://www.orz123.net/item/9nzX46cODoY4jdSXk.html
https://www.orz123.net/item/9nzX46cOPag0QgKFr4.html
https://www.orz123.net/item/gWPKrZuA3D7bW7rhGq.html
https://www.orz123.net/item/ZXrKBOuAYnXoajvIN.html
https://www.orz123.net/item/pZBA9NuRJmeA5BJhj4.html
https://www.orz123.net/item/0rv0ZOuBZJWwaYrfj.html
https://www.orz123.net/item/pZBA9NugZB6dayetq4.html
https://www.orz123.net/item/rJXxVWS7Yr60mqFJ.html
https://www.orz123.net/item/yJ3MYPS6yMwyrj3cb.html
https://www.orz123.net/item/7xna4KtwrdPeQWwSV4.html
https://www.orz123.net/item/zjDyYMTorm8AN0MuJ9.html
https://www.orz123.net/item/bwXgxjiG9k85RpQhWB.html
https://www.orz123.net/item/O3qo7PTZ25Ozq2kC8r.html
https://www.orz123.net/item/rJXxVWSMqgKkMw9C9.html
⭐小红书推荐⭐私处清洗液男性清洁抑菌日常私护洗护液止痒私密处护理液杀菌 男士,所属私处洗液分类,由淘宝网挑选推荐!小红书抖音网红同款!哪里有卖私处清洗液男性清洁抑菌日常私护洗护液止痒私密处护理液杀菌 男士和多少钱质量怎么样✅。 妇炎洁私处清洗液女私密护理液外阴清洁益生菌洗液女性日常洗护液 妇炎洁私处洗护液女性护理清洗液冲洗抑菌止痒私密清洗剂官方正品 私处护理清洗液男性清洁抑菌私密沐浴露日常抑菌洗护液 妇炎洁男士 蔓越莓私处洗护液私密护理液护理日常清洗液女性去异味官方正品 妇炎洁男士 私处护理液私密清洗液沐浴露便携清洁液60g 天猫U先 妇炎洁私处洗护液女泡沫慕斯益生菌洗液日常私密护理液私处清洗液 宫本武藏蔓越莓私密护理女性益生菌呵护私处清洗液官方旗舰店正品 妇炎洁私处清洗液洗护液女性抑菌可内外阴清洗私密护理液官方正品 妇炎洁雪莲抑霉菌私处清洗液女性私密护理液外阴清洁洗剂洗护洗液 洁尔阴女性私处洗护私部护理液清洗外阴女日常私密洗液洗私洁阴 毓婷私处洗护液私密护理液外阴清洗液女日常洗护妇科洗液私处护理 妇炎洁女性私处清洗液私密部日常护理液本草抑菌680ml 瓶官方正品 intima茵缇玛私处洗护液私密护理液私处日常洗护沐浴露清洗液女性 海洋至尊男士 私处护理清洗液清洁抑菌洗下面私密便携 明星同款 妇炎洁私处清洗液女私护清洁液益生菌私密护理液抑菌止痒日常洗护




https://www.orz123.net/item/9nzX46cODoY4jdSXk.html
https://www.orz123.net/item/9nzX46cOPag0QgKFr4.html
https://www.orz123.net/item/gWPKrZuA3D7bW7rhGq.html
https://www.orz123.net/item/ZXrKBOuAYnXoajvIN.html
https://www.orz123.net/item/pZBA9NuRJmeA5BJhj4.html
https://www.orz123.net/item/0rv0ZOuBZJWwaYrfj.html
https://www.orz123.net/item/pZBA9NugZB6dayetq4.html
https://www.orz123.net/item/rJXxVWS7Yr60mqFJ.html
https://www.orz123.net/item/yJ3MYPS6yMwyrj3cb.html
https://www.orz123.net/item/7xna4KtwrdPeQWwSV4.html
https://www.orz123.net/item/zjDyYMTorm8AN0MuJ9.html
https://www.orz123.net/item/bwXgxjiG9k85RpQhWB.html
https://www.orz123.net/item/O3qo7PTZ25Ozq2kC8r.html
https://www.orz123.net/item/rJXxVWSMqgKkMw9C9.html
淘宝网为您提供商品私处清洗液男性清洁抑菌日常私护洗护液止痒私密处护理液杀菌 男士的详细介绍,
折后价格89元,已有0人购买,选自掌柜国货严选旗舰,
淘宝网为您提供淘宝网网上热销商品,让您更快找到热门以及合适自己的商品,
特别提供商品的详细参数、介绍以及报价等信息,挑选商品更方便。